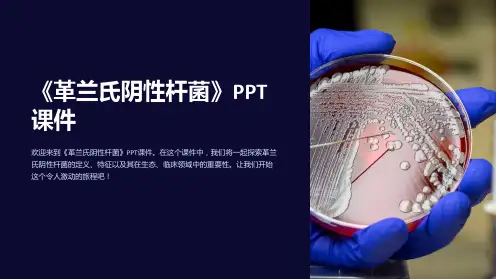

• 由泌尿、生殖系统来源的标本中分离出的G-双球菌,可初步 诊断为淋球菌
脓汁或 喉拭子
涂片、革兰染色、镜检
血琼脂平板
37℃ 24h 观察菌落特征
及溶血情况
生化反应、致病力试验及药敏试验
葡萄球菌鉴别
金黄色葡萄球菌 表皮葡萄球菌
色素
金黄色 白色
α-溶血素
+
血浆凝固酶试验 +
耐热DNA酶试验 +
甘露醇发酵试验 +
• 生物学特性
– 形态染色:与脑膜炎奈瑟菌相似, G—,双球菌,咖啡豆 状,有荚膜和菌毛,无芽胞,无鞭毛 脓汁标本中 急性病人:细菌位于中性粒细胞内 慢性病人:细菌位于细胞外
– 培养特性:与脑膜炎奈瑟菌相似,营养要求更高,只能在 巧克力平板及专用培养基上生长,形成灰白色细小S型菌 落
– 生化反应:氧化酶(+),只分解葡萄糖,不分解麦芽糖 (脑膜炎奈瑟菌分解麦芽糖)等其它糖类
4.Optochin抑制试验:
抑菌环中也微弱的生长了些菌落,但经过涂片发现是口腔球菌.可 能是做该试验的同事挑菌落的时候,没把握好.把杂菌带进去了.尽 管如此,抑菌环还是非常明显而宽大(22mm).
5.生化反应:
用的就是普通微量管,在接种前滴加小牛血清1 滴.5%CO2,35℃培养18~24h后读取并记录结果.
– 抗原及分类:以外膜蛋白抗原分16个血清型 – 抵抗力:极弱(与脑膜炎奈瑟菌相似)
淋病奈瑟菌鉴定依据:
➢ 1. 涂片染色为革兰阴 性双球菌;
➢ 2. 巧克力平板上为半 透明、灰白色、凸 起滴露状菌落;
➢ 3. 氧化酶及触酶均阳 性;
➢ 4. 只分解葡萄糖,产 酸不产气;
➢ 5. 血清学试验阳性。